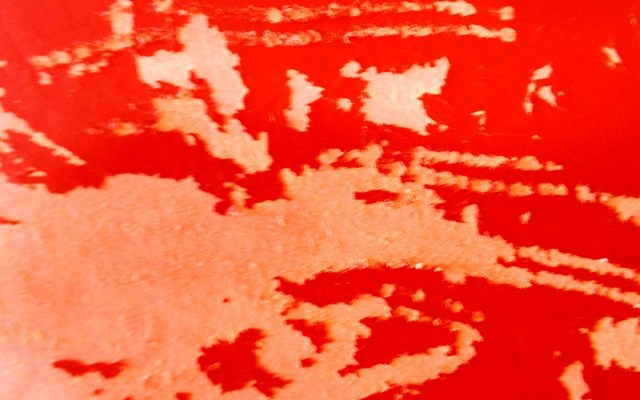

© Roberto Alborghetti – – Close-up photography; this is not a digitally created, manipulated or enhanced image. – Scatto fotografico a distanza ravvicinata; non è un’immagine manipolata o creata digitalmente.
There is a free and spontaneous form of art that flows before our eyes every day, perhaps without us realizing it.
It is the one that appears on the things that surround us and that perhaps we use every day. It is that of materials and street furniture, present in all our cities. They are all those “signs of the times” that I like to capture and document for my project “Lacer/actions”.
I think that all this can be defined as minor (poor) art that reveals itself on deteriorated things, on which the passage of time leaves its signature, its imprint. All this has been documented for years in the “Lacer/actions” project, for which I have so far collected over 150,000 images (photographs, macro photographs and close-up photographs) taken so far around cities around the world.
Our cities and metropolises are also told through decompositions, the lacerations and corrosions caused by humans and time. Often, these things are not easy to see. We just need to keep our attention and perception of what surrounds us high. At that point you can see interesting and captivating images, expressions of colors and shapes in which I have no difficulty recognizing what we usually call “contemporary art”. So, in this photographic series, here is “art about things”: images from the largest art gallery in the world. The one outdoors every day along the streets of cities around the world.

*
C’è una forma d’arte libera e spontanea che ci scorre quotidianamente sotto glI occhi, senza forse che ce ne rendiamo conto.
E’ quella che appare sulle cose che ci circondano e che magari usiamo ogni giorno. E’ quella dei materiali e degli arredi urbani, presenti in tutte le nostr città. E’ quella dei “segni del tempo” che mi piace catturare e documentare per il mio progetto “Lacer/actions”. Penso che tutto ciò possa essere definito come l’arte minore (povera) che si rivela sulle cose deteriorate, su cui lo scorrere del tempo lascia la sua firma, la sua impronta. Tutto ciò è documentato, da anni, nel progetto “Lacer/actions”, per il quale ho finora raccolto oltre 150.000 immagini (fotografie, macrofotografie e fotografie ravvicinate) scattate finora in giro per le città del mondo. Le nostre città e metropoli si raccontano anche attraverso le decomposizioni, le lacerazioni e le corrosioni causate dagli esseri umani e dal tempo. Spesso, queste cose, non sono facili da vedere. Occorre solo mantenere alta l’attenzione e la percezione di ciò che ci circonda. A quel punto si possono scorgere immagini interessanti e catturanti, espressioni di dei colori e forme in cui non fatico a riconoscere ciò che solitamente noi chiamiamo “arte contemporanea”. Quindi, in questa serie fotografica, ecco “l’arte sulle cose”: immagini provenienti dalla più grande galleria d’arte del mondo. Quella all’aperto ogni giorno lungo le strade delle città del mondo. Buona visione!
